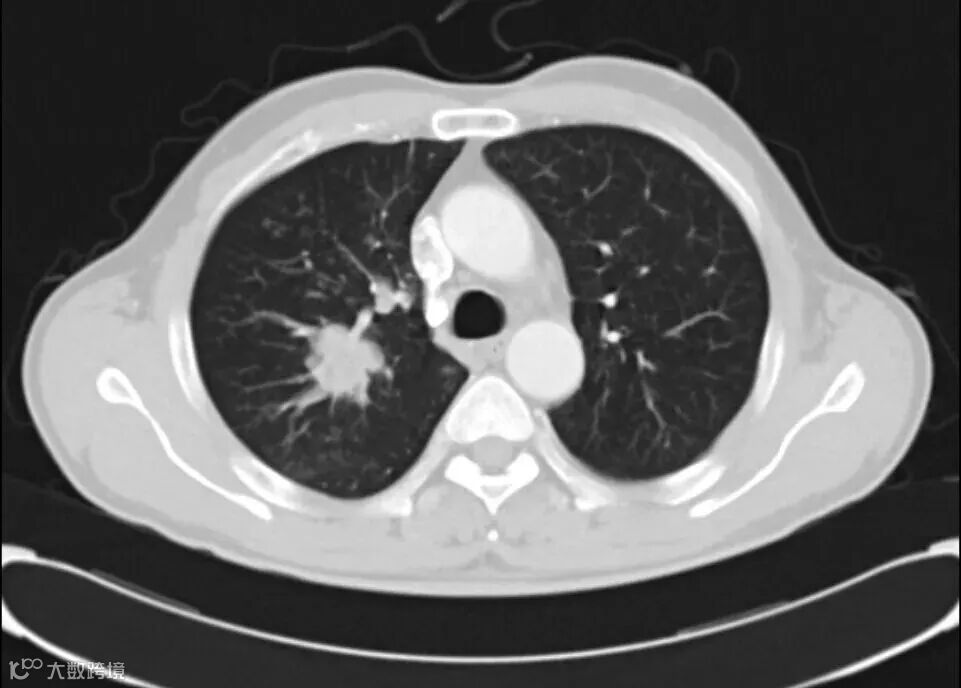

一、瑞普替尼纳入医保,意义重大

2024 年 11 月 28 日,国家医保局公布的新版医保目录名单中,瑞普替尼赫然在列,这一消息如同一束希望之光,照亮了众多 ROS1 肺癌患者前行的道路。从 2025 年 1 月 1 日起,符合条件的患者接受瑞普替尼治疗可以通过医保报销。这意味着,曾经因高昂药价而对这款药物望而却步的患者,如今有了更多接受有效治疗的机会。
此前,瑞普替尼虽于 2024 年 5 月获批上市,为 ROS1 阳性的局部晚期或转移性非小细胞肺癌成人患者带来了新的治疗希望,但其高昂的价格却成为了患者用药的一大障碍。美国媒体报道其月费用高达 29000 美元,国内报道也高达 26 万人民币 ,这样的费用让许多患者家庭不堪重负。纳入医保后,患者的经济压力将得到极大缓解,更多人能够及时用上这款有效的治疗药物,从而提升整体的治疗可及性。

二、ROS1 肺癌困境与挑战
ROS1 肺癌作为非小细胞肺癌中的一种特殊类型,其发病率在肺癌患者中占比约 1%-2% ,虽然比例相对不高,但由于肺癌整体患病人数众多,这一群体的数量也不容小觑。且 ROS1 阳性患者往往呈现出一定的特征,多为较年轻、不吸烟的肺腺癌患者,平均发病年龄为 50 岁左右,女性患者占比较高。
在治疗方面,ROS1 肺癌患者面临着诸多严峻的挑战。耐药问题一直是困扰 ROS1 肺癌治疗的一大难题。以克唑替尼为例,它是第一代用于治疗 ROS1 重排的非小细胞肺癌的靶向药物,在治疗初期,患者通常能获得较为显著的疗效,客观缓解率较高,能有效控制病情发展。然而,随着时间的推移,大部分患者在使用克唑替尼 1-2 年后会出现耐药情况。耐药后,病情会出现不同程度的进展,如肿瘤再次增大、出现新的转移病灶等。
当克唑替尼耐药后,可供选择的后续治疗方案十分有限。传统的化疗手段虽然对部分患者有一定效果,但化疗在杀死癌细胞的同时,也会对正常细胞造成较大损伤,导致患者出现一系列严重的不良反应,如恶心、呕吐、脱发、骨髓抑制等,严重影响患者的生活质量。且化疗的有效率相对较低,无法为患者带来长期的生存获益。
此外,ROS1 肺癌患者发生脑转移的几率相对较高。由于血脑屏障的存在,很多药物难以有效进入脑部,对脑转移病灶进行控制。一旦发生脑转移,患者的预后往往较差,会出现头痛、头晕、视力下降、肢体无力等症状,严重影响患者的生活自理能力和认知功能,进一步降低患者的生活质量和生存期。这些困境使得 ROS1 肺癌患者急需更有效的治疗药物和方案,以改善他们的生存状况和生活质量。

三、瑞普替尼:治疗机制与优势

(一)作用机制
瑞普替尼是一种受体酪氨酸激酶抑制剂,其作用机制犹如一把精准的 “分子钥匙”,专门针对 ROS1 基因重排阳性的肺癌患者。当 ROS1 基因发生重排时,会产生异常的融合蛋白,这些融合蛋白就像被按下了 “启动键”,持续激活下游的信号传导通路,促使癌细胞不断增殖、生长和扩散 。
瑞普替尼能够高度选择性地与 ROS1 融合蛋白相结合,如同给异常活跃的 “发动机” 装上了 “刹车装置”,阻止其异常激活信号的传递。这一过程有效切断了癌细胞生长的 “动力源”,从而抑制肿瘤细胞的增殖,诱导其凋亡,进而达到控制肿瘤生长的目的。与第一代 ROS1 靶向药物相比,瑞普替尼在抑制肿瘤生长方面具有更强的活性,它对 ROS1 融合蛋白的抑制作用更为精准和高效,为患者带来了更显著的治疗效果。
(二)临床疗效显著
大量的临床研究数据充分展示了瑞普替尼在治疗 ROS1 肺癌方面的卓越疗效。在未经治疗的 ROS1 阳性非小细胞肺癌患者中,瑞普替尼展现出了令人瞩目的客观缓解率,高达约 80% 。这意味着近 80% 的患者在接受瑞普替尼治疗后,肿瘤出现了明显的缩小甚至消失。
对于那些已接受过克唑替尼治疗并发生耐药的患者,瑞普替尼依然能发挥显著作用,总有效率仍达到约 60% 。这一数据为耐药患者带来了新的希望,使他们在面临治疗困境时,有了继续对抗疾病的有力武器。
中位无进展生存期(PFS)和中位缓解持续时间(DoR)是评估肿瘤治疗效果的重要指标。在 ROS1 阳性非小细胞肺癌患者中,瑞普替尼的表现十分出色,中位无进展生存期长达 35.7 个月,中位缓解持续时间也达到了 34.1 个月 。这意味着患者在接受瑞普替尼治疗后,能够在较长时间内保持病情稳定,不出现疾病进展,并且缓解的状态能够持续较长时间,极大地提高了患者的生活质量和生存期。
此外,瑞普替尼在针对脑转移患者的治疗中也表现突出。由于血脑屏障的存在,许多药物难以有效进入脑部发挥作用,但瑞普替尼凭借其独特的分子结构和良好的穿透能力,能够有效穿透血脑屏障。在基线时可测量脑转移的患者中,未接受 TKI 治疗的患者中有较高比例观察到了颅内应答;接受过 TKI 治疗的患者中,也有相当一部分患者实现了颅内应答。TRIDENT - 1 研究最新结果显示,瑞普替尼在基线时可测量脑转移患者中的颅内客观缓解率(ORR)高达 89%,且缓解时间长,不仅能够有效控制脑部肿瘤的生长,还可能延迟或阻止基线无脑转移患者的脑部病灶发展,为脑转移患者带来了更好的治疗前景。

四、老挝卢修斯仿制版瑞普替尼详情

(一)价格揭秘
老挝卢修斯仿制版瑞普替尼为众多患者带来了更经济的治疗选择。由于其无需承担原研药高昂的研发成本,价格相对亲民。据相关资料显示,老挝卢修斯仿制版瑞普替尼每盒价格在 3000 元不到 。这与原研药高达 24570 美元(约合人民币超百万元,以每盒 40mg120 粒规格计算)的价格相比,具有极大的优势,大大减轻了患者的经济压力,让更多患者有机会获得有效的治疗。
(二)购买渠道指南
药品咨询服务👇 在线人工客服👇

长图图片识别二维码联系在线客服
或点击下方阅读原文,咨询在线客服
虽然老挝卢修斯仿制版瑞普替尼尚未在国内上市,但国内患者仍有合法途径购买。
1.认证药房:可选择通过老挝国政府及国际相关机构认证的正规药房或在线药店购买。这些药房通常会在其官方网站或实体店面展示认证信息,如药品监管局的批准文号等,这是药品合法性和质量的直接证明。患者在购买时,务必仔细查看这些认证标识,确保药品来源可靠。
2.官方授权经销商:查找并联系老挝卢修斯瑞普替尼生产厂商的官方授权经销商。这些经销商与厂家有直接的进货渠道,能够保证药品的真实性和供应链的透明度。患者可以通过老挝卢修斯官方网站查询授权经销商的联系方式,或者咨询专业的医疗顾问获取相关信息。
3.医生推荐:患者可咨询自己的主治医生或肿瘤专家,他们凭借丰富的专业经验和临床资源,可能为患者提供可靠的购买建议,甚至直接推荐值得信赖的购药途径。医生的专业建议对于确保患者治疗效果和用药安全至关重要,患者应充分重视。
4.国际医疗服务平台:一些国际认可的医疗服务平台与多个国家的药房建立了合作关系,能够提供包括老挝瑞普替尼在内的多种药物。这些平台通常会对合作药房进行严格审核,以确保药品质量和供应的稳定性。在选择国际医疗服务平台时,患者要选择知名度高、口碑好的平台,并仔细了解平台的服务条款和药品保障措施 。

五、瑞普替尼详细说明书解读

(一)基本信息
瑞普替尼通常为胶囊剂型,以老挝卢修斯仿制版为例,常见规格为每粒 40mg,一盒有 160 粒 。其主要成分为 repotrectinib,这是一种新型的口服、小分子、多靶点的酪氨酸激酶抑制剂(TKI) ,专门针对癌细胞中异常活跃的基因发挥作用。在储存方面,需将其置于 20°C - 25°C 的环境中,允许的温度波动范围为 15°C - 30°C ,以确保药品的稳定性和有效性,保质期一般为 36 个月。患者在使用前,务必仔细检查药品的包装是否完好,查看生产日期和有效期,避免使用过期或变质的药物。
(二)用法用量
对于 ROS1 阳性的局部晚期或转移性非小细胞肺癌患者,瑞普替尼的标准服用方案为:初始阶段,每日 1 次,每次口服 160mg,持续服用 14 天。在这 14 天的治疗过程中,医生会密切观察患者对药物的耐受情况,包括是否出现不良反应及其严重程度等。若患者能够较好地耐受药物,14 天后,剂量将增加至每日 2 次,每次 160mg ,并持续用药直至疾病出现进展,或者患者出现不可耐受的反应。
患者在服用瑞普替尼时,应尽量保持每天在同一时间用药,以维持药物在体内的稳定血药浓度,确保药物疗效的稳定性。需用整杯水送服胶囊,严禁打开、挤压、咀嚼或溶解胶囊,因为这些不当操作可能会破坏药物的剂型结构,影响药物的正常释放和吸收过程,进而降低药物的疗效,甚至可能引发一些不必要的不良反应。若不小心发现胶囊出现破碎、破裂或损坏的情况,应坚决避免服用,以防摄入异常剂量的药物,对身体造成损害。此外,如果患者错过了某一剂药物,或者在服药后发生呕吐,无需额外补服药物,只需按照原计划的时间继续服用下一剂即可,切不可为了弥补遗漏或呕吐的剂量,而在同一时间内服用两剂药物,以免因药物剂量过大而导致严重的不良反应。
需要特别强调的是,以上用法用量仅为一般推荐,由于每位患者的病情严重程度、身体状况、对药物的反应等都存在个体差异,所以具体的服用剂量和疗程,必须严格遵循医生的专业医嘱。医生会根据患者的全面情况,制定出最适合患者的个性化治疗方案,以达到最佳的治疗效果,同时最大程度保障患者的用药安全。
(三)特殊人群用药
1.孕妇:瑞普替尼可能对胎儿造成严重伤害,因此孕妇应绝对避免使用此药。在怀孕过程中,胎儿的各个器官和系统处于快速发育和形成的关键时期,药物的任何潜在不良影响都可能导致胎儿出现发育异常、畸形等严重后果。如果女性患者在使用瑞普替尼治疗期间发现怀孕,应立即告知医生,医生会根据具体情况,权衡继续用药对胎儿的风险以及停药对患者病情的影响,制定出最为合适的应对措施。
2.哺乳期女性:目前尚不清楚瑞普替尼是否会通过母乳传递给婴儿,以及是否会对婴儿产生不良影响。为了确保婴儿的安全,建议哺乳期女性在接受瑞普替尼治疗期间以及末次给药后的一段时间内,停止母乳喂养。在停止母乳喂养期间,母亲应注意采取适当的措施,如使用吸奶器等,以维持乳汁的分泌,避免出现乳汁淤积等问题,待治疗结束且医生评估安全后,再考虑恢复母乳喂养。
3.儿童:对于 ROS1 阳性非小细胞肺癌的儿童患者,瑞普替尼的治疗效果和安全性尚未得到充分的研究和确定。儿童的身体机能和代谢特点与成人存在较大差异,药物在儿童体内的吸收、分布、代谢和排泄过程可能与成人不同,因此在没有明确的研究数据支持之前,不建议对儿童使用瑞普替尼。若儿童患者被诊断为 ROS1 阳性非小细胞肺癌,医生会根据其具体情况,综合考虑其他更适合儿童的治疗方案。
4.老人:65 岁以下与 65 岁及以上患者在使用瑞普替尼时,治疗效果在临床研究中并未观察到显著差异 。然而,老年人的身体机能通常会有所衰退,可能存在多种基础疾病,且肝肾功能也可能相对较弱,这可能会影响药物在体内的代谢和排泄过程。因此,在为老年患者使用瑞普替尼时,医生会更加谨慎地评估其身体状况,密切监测药物的不良反应,根据需要及时调整药物剂量,以确保治疗的安全性和有效性。
5.肝肾功能受损患者:对于轻度肝损害患者,目前一般不建议调整瑞普替尼的剂量。但对于中度和重度肝损害患者,由于肝脏对药物的代谢能力明显下降,药物在体内的浓度可能会升高,从而增加不良反应的发生风险,因此瑞普替尼的推荐剂量尚未确定,医生会根据患者的具体肝功能情况,谨慎制定个体化的治疗方案。
对于肾功能方面,轻度或中度肾损害患者,通常不建议调整剂量。但对于重度肾损害或肾衰竭患者,由于肾脏无法正常有效地排泄药物及其代谢产物,药物在体内的蓄积可能会导致严重的不良反应,所以瑞普替尼的推荐剂量也尚未明确,医生会综合评估患者的肾功能状况、整体病情以及药物的潜在风险和获益,来决定是否使用瑞普替尼以及如何调整剂量。
(四)药物相互作用
1.强效和中效 CYP3A 抑制剂:这类药物如酮康唑、伊曲康唑、克拉霉素等,会抑制体内 CYP3A 酶的活性。当瑞普替尼与强效和中效 CYP3A 抑制剂合并使用时,CYP3A 酶对瑞普替尼的代谢作用受到抑制,导致瑞普替尼在血浆中的浓度升高。这不仅会增加不良反应的发生率,还可能使不良反应的严重程度加剧,对患者的身体健康造成严重威胁。因此,在开始瑞普替尼治疗前,患者应停用 CYP3A 抑制剂 3 至 5 个消除半衰期,以确保 CYP3A 酶活性恢复到正常水平,最大程度降低药物相互作用的风险。
2.P - gp 抑制剂:例如环孢素、维拉帕米等 P - gp 抑制剂,与瑞普替尼合用时,会增加瑞普替尼在体内的暴露量。这意味着药物在体内的浓度会升高,从而增加了不良反应发生的风险。为了保障用药安全,应避免瑞普替尼与 P - gp 抑制剂合并使用。
3.强效和中效 CYP3A 诱导剂:像利福平、苯妥英钠等强效和中效 CYP3A 诱导剂,会诱导 CYP3A 酶的活性增强。当瑞普替尼与这类药物同时使用时,CYP3A 酶会加速瑞普替尼的代谢,导致其血浆浓度降低。血浆浓度过低可能会使瑞普替尼无法达到有效的治疗浓度,从而影响其对肿瘤的抑制作用,降低治疗效果。所以,应避免瑞普替尼与强效和中效 CYP3A 诱导剂合并使用。
4.某些 CYP3A4 底物:瑞普替尼作为 CYP3A4 诱导剂,可能会降低同时使用的 CYP3A4 底物(如咪达唑仑、硝苯地平等)的血浆浓度。这将导致这些底物药物的疗效降低,无法发挥其应有的治疗作用。如果患者因病情需要,无法避免同时使用瑞普替尼和 CYP3A4 底物药物,应根据药品批准的产品标签和医生的专业建议,采取适当的措施,如调整药物剂量、密切监测药物疗效等,以维持 CYP3A4 底物的治疗效果。
5.避孕药:瑞普替尼能够降低孕激素或雌激素的暴露量,进而降低激素避孕药的有效性。对于有避孕需求的女性患者,在使用瑞普替尼治疗期间,应避免使用激素避孕药,建议采用有效的非激素避孕方法,如避孕套、宫内节育器等,以防止意外怀孕的发生。

六、瑞普替尼副作用及应对措施
(一)常见副作用
在使用瑞普替尼的过程中,部分患者可能会出现一些副作用 。常见的副作用包括:
1.头晕:这是较为常见的神经系统反应,约 58% 的患者会出现 。可能由药物对中枢神经系统的直接影响或血压变化等生理机制引起。头晕程度因人而异,轻者可能只是偶尔感到头部昏沉,对日常活动影响较小;重者可能会严重影响平衡感和日常活动能力,增加跌倒的风险。
2.味觉障碍:大约 50% 的患者会遭遇此问题 。患者可能会感觉食物味道发生改变,变得平淡无味,或者对某些食物产生厌恶感,从而影响对食物的喜好和摄入量,进而影响营养摄入和体重管理。
3.周围神经病变:约 30% 的患者会受到影响 。主要表现为手脚感觉异常,如麻木、刺痛或烧灼感,严重时可能会影响手脚的正常活动,降低患者的生活质量。
4.便秘:有 36% 的患者会出现便秘症状 。这可能导致患者排便困难、腹部不适,严重时会影响食欲和消化功能。
5.呼吸困难:约 30% 的患者会经历呼吸困难 。轻者可能在活动后感到气短,重者即使在休息时也会觉得呼吸不畅,对患者的日常生活和睡眠造成较大困扰。
6.共济失调:28% 的患者会出现共济失调,表现为患者的平衡感和协调能力下降,行走时可能会出现摇晃不稳的情况,增加了摔倒受伤的风险。
7.疲劳:24% 的患者会感到疲劳 。这种疲劳感可能持续存在,即使经过充分休息也难以完全缓解,导致患者精神状态不佳,影响日常的工作和生活。
8.认知障碍:23% 的患者可能出现认知障碍,如记忆力减退、注意力不集中等,对患者的学习、工作和社交活动产生不利影响。
9.肌无力:约 21% 的患者会出现肌无力症状 。患者会感觉肌肉力量减弱,进行日常活动,如上下楼梯、提重物等,会变得较为吃力。
10.头痛:19% 的患者会遭受头痛的困扰 。头痛的程度和性质各不相同,可能是轻微的胀痛,也可能是较为剧烈的搏动性疼痛,严重时会影响患者的休息和生活质量。
11.恶心:同样有 19% 的患者会出现恶心症状 。患者常常会有想呕吐的感觉,尤其是在进食后,可能会导致食欲下降,影响营养的摄取。
12.咳嗽:14% 的患者会出现咳嗽症状 。咳嗽可能是偶尔的干咳,也可能伴有痰液,严重时会影响患者的呼吸和睡眠。
13.腹泻:13% 的患者会经历腹泻 。腹泻可能导致患者身体脱水、电解质紊乱,影响身体健康。
14.水肿:约 12% 的患者会出现水肿 。常见于下肢、脚踝等部位,表现为局部肿胀,按压后可能会出现凹陷。
15.肌肉疼痛:12% 的患者会感到肌肉疼痛 。疼痛可能发生在身体的不同部位,如四肢、腰背等,程度轻重不一,影响患者的活动能力和舒适度。
(二)应对策略
面对这些副作用,患者不必过于恐慌,可采取以下相应的应对措施:
1.头晕:当出现头晕症状时,患者首先要避免进行一些危险的活动,如驾驶、操作重型机械等,以防发生意外。尽量多休息,保证充足的睡眠,避免长时间站立或突然改变体位。起身时动作要缓慢,避免因体位性低血压导致头晕加重。如果头晕症状持续不缓解或加重,应及时告知医生,医生可能会根据情况调整药物剂量或采取其他治疗措施。
2.味觉障碍:患者可以尝试使用一些香料或调味品来增加食物的口感,提升食欲,如柠檬汁、醋、胡椒粉等。选择营养丰富且易于消化的食物,如瘦肉粥、鸡蛋羹、蔬菜汤等,保证营养摄入。也可以尝试改变食物的烹饪方式,以不同的口味刺激味觉。若味觉障碍严重影响进食和营养状况,应及时与医生沟通,寻求进一步的建议。
3.周围神经病变:一旦出现手脚麻木、刺痛或烧灼感等周围神经病变症状,患者应及时就医并告知医生。医生可能会根据具体情况调整药物剂量,或开具一些营养神经的药物,如甲钴胺等,以缓解症状。患者在日常生活中要注意手脚的保暖,避免接触过冷或过热的物品,防止加重不适。同时,可以适当进行一些手脚的活动和按摩,促进血液循环。
4.便秘:患者要增加膳食纤维的摄入,多吃新鲜蔬菜(如菠菜、西兰花、芹菜等)、水果(如苹果、香蕉、梨等)和全谷类食物(如燕麦、糙米、全麦面包等)。保证充足的水分摄入,每天至少饮用 1500 - 2000 毫升的水,以保持肠道湿润。适当增加运动量,如散步、慢跑、瑜伽等,有助于促进肠道蠕动。如果便秘症状严重,可在医生的指导下使用一些缓泻剂,如乳果糖、开塞露等。
5.呼吸困难:患者应立即休息,避免剧烈运动。保持室内空气流通,可适当开窗通风或使用空气净化器。如果呼吸困难症状较轻,可尝试通过调整呼吸方式,如深呼吸、腹式呼吸等,来缓解不适。若症状持续不改善或加重,应及时就医,医生可能会进行相关检查,如胸部 X 光、血气分析等,以明确病因,并给予吸氧、药物治疗等相应的处理措施。
6.共济失调:患者在行走时要特别小心,可使用拐杖或助行器辅助行走,增加稳定性,防止摔倒。避免在光线昏暗或地面湿滑的环境中行走。进行一些平衡训练,如站立在平衡垫上、单脚站立等,有助于提高平衡能力。同时,要及时向医生反馈症状,医生会根据病情调整治疗方案。
7.疲劳:保证充足的休息和睡眠,每天尽量保证 7 - 8 小时的睡眠时间。合理安排日常活动,避免过度劳累,可将活动分成小段时间进行,中间适当休息。增加营养摄入,多吃富含蛋白质、维生素和矿物质的食物,如鸡肉、鱼肉、豆类、坚果等,以补充身体能量。如果疲劳症状严重影响生活,可在医生的建议下,适当调整药物剂量或进行一些针对性的调理。
8.认知障碍:患者可以尝试进行一些认知训练,如阅读、下棋、玩拼图游戏等,有助于锻炼大脑功能,提高记忆力和注意力。保持良好的生活习惯,规律作息,避免熬夜。家人要给予患者更多的关心和支持,帮助患者进行日常生活管理。若认知障碍症状加重,应及时告知医生,医生可能会进行相关评估,并采取相应的治疗措施,如调整药物或给予其他干预。
9.肌无力:患者应避免过度劳累,减少重体力劳动和剧烈运动。进行适当的康复训练,如进行一些简单的肌肉力量练习,如抬腿、握拳等,但要注意运动强度适中,避免造成肌肉损伤。增加蛋白质的摄入,多吃一些富含优质蛋白质的食物,如牛奶、鸡蛋、牛肉等,有助于肌肉的修复和生长。若肌无力症状持续不缓解或加重,需及时就医,医生会根据具体情况进行评估和处理。
10.头痛:患者要注意休息,可找一个安静、舒适的环境,闭上眼睛放松身心,缓解头痛症状。避免精神紧张和焦虑,可通过听音乐、冥想等方式放松心情。如果头痛较轻,可以尝试用热敷或冷敷的方法缓解,如用热毛巾敷在额头或用冰袋敷在太阳穴部位。若头痛严重,可在医生的指导下服用一些止痛药物,如对乙酰氨基酚等,但要注意避免自行滥用止痛药。
11.恶心:患者在饮食上要注意少食多餐,避免一次进食过多。选择清淡、易消化的食物,避免食用油腻、辛辣、刺激性食物。可以在饭前或饭后适当吃一些姜片,姜具有一定的止呕作用。如果恶心症状严重,可在医生的指导下使用一些止吐药物,如胃复安等。
12.咳嗽:患者要多喝水,保持呼吸道湿润,有助于稀释痰液,缓解咳嗽症状。避免接触刺激性气体,如烟雾、粉尘等,外出时可佩戴口罩。如果咳嗽较轻,可以尝试饮用一些蜂蜜水、冰糖雪梨汤等,有一定的润肺止咳作用。若咳嗽持续不缓解或伴有发热、呼吸困难等症状,应及时就医,进行相关检查,如胸部 CT 等,以明确病因,并给予相应的治疗。
14.腹泻:患者要注意饮食卫生,避免食用不洁食物。饮食宜清淡,减少油腻、辛辣、生冷食物的摄入。增加水分摄入,可饮用一些淡盐水、米汤等,以防止脱水和电解质紊乱。如果腹泻次数较多或症状严重,应及时就医,医生可能会根据情况给予止泻药物,如蒙脱石散等,并进行相关检查,以排除其他病因。
15.水肿:患者要减少盐的摄入,每天的食盐摄入量应控制在 3 - 5 克。避免长时间站立或久坐,休息时可将下肢抬高,促进血液回流,减轻水肿症状。如果水肿持续不消退或加重,应及时就医,医生会进行相关检查,如肾功能、心脏功能检查等,以明确病因,并给予相应的治疗,如使用利尿剂等。
15.肌肉疼痛:患者要注意休息,避免过度活动导致肌肉疼痛加重。可以对疼痛部位进行热敷或按摩,促进血液循环,缓解肌肉紧张。若疼痛严重,可在医生的指导下使用一些止痛药物,如布洛芬等。如果肌肉疼痛伴有发热、乏力等其他症状,应及时就医,以排除其他疾病的可能。
总之,患者在使用瑞普替尼治疗期间,要密切关注自身身体状况,如出现任何不适症状,应及时与医生沟通,在医生的指导下采取相应的应对措施,以确保治疗的顺利进行和自身的健康安全。

七、瑞普替尼医保报销政策解析

(一)报销条件
根据医保政策规定,患者若想通过医保报销瑞普替尼的费用,需满足以下条件:必须经正规医疗机构确诊为 ROS1 阳性的局部晚期或转移性非小细胞肺癌成人患者。这一诊断需通过专业的基因检测技术来确定,如荧光原位杂交(FISH)、聚合酶链式反应(PCR)等方法,以精准检测出患者体内 ROS1 基因的重排情况 。只有确诊为该疾病类型且符合医保报销范围的患者,才有资格申请瑞普替尼的医保报销。
(二)报销比例与流程
1.报销比例:不同地区的医保报销比例存在一定差异。一般而言,瑞普替尼的报销比例在 50% - 70% 左右 。例如,在一些经济较为发达、医保政策较为完善的地区,报销比例可能高达 70% 。这意味着患者只需承担 30% 的药物费用,大大减轻了经济负担。以每月药物费用 2 万元为例,报销后患者每月仅需支付 6000 元。而在部分地区,报销比例可能相对较低,为 50% ,患者每月需支付 1 万元。具体的报销比例,患者可咨询当地医保部门或就诊医院的医保办公室,以获取准确信息。
2.报销流程:
准备材料:患者首先要准备一系列申请报销所需的材料。包括由主治医生开具的诊断证明,明确注明患者所患疾病为 ROS1 阳性的局部晚期或转移性非小细胞肺癌;完整的基因检测报告,详细展示 ROS1 基因的检测结果,以证明患者符合用药的基因条件;医生开具的处方,清晰记录瑞普替尼的使用剂量、疗程等信息;患者本人的身份证、医保卡,用于确认患者的身份和医保参保信息;购药发票及明细清单,明确显示购买瑞普替尼的时间、地点、金额等详细信息,确保药品费用的真实性和可追溯性。
提交申请:患者准备好上述材料后,将其提交至当地医保部门指定的地点或通过医保部门认可的线上平台进行申请。在一些地区,患者可直接将材料提交至就诊医院的医保结算窗口,由医院工作人员协助办理报销申请手续。部分地区则需患者前往当地医保局的办事大厅,在专门的窗口提交申请材料。在提交申请时,患者务必确保材料的完整性和准确性,如有遗漏或错误,可能会导致申请审核不通过,延误报销时间。
审核与报销:医保部门在收到患者的报销申请后,会对提交的材料进行严格审核。审核内容包括患者的疾病诊断是否符合报销标准、基因检测报告的真实性和有效性、处方的规范性以及购药发票的合法性等。这一审核过程通常需要一定时间,一般在 15 - 30 个工作日左右 。若审核通过,医保部门将按照当地规定的报销比例,将报销款项支付给患者或直接支付给提供药品的医疗机构。支付方式可能为银行转账,将报销款直接打入患者提供的银行账户中;也可能在医院结算时,直接抵扣患者的医疗费用,患者只需支付自付部分的金额。

八、总结与展望
瑞普替尼纳入医保,无疑为 ROS1 肺癌患者带来了诸多积极影响。它不仅显著减轻了患者的经济负担,使更多患者能够获得有效的治疗,还在一定程度上提升了患者的治疗信心和生活质量。对于患者而言,在后续的治疗过程中,积极与医生沟通至关重要。患者应将自身的身体状况、用药反应等详细信息及时反馈给医生,以便医生根据实际情况调整治疗方案,确保治疗的安全性和有效性。同时,患者要严格按照医生的嘱咐合理使用药物,切不可自行增减剂量或停药,以免影响治疗效果。
展望未来,随着医学研究的不断深入,肺癌治疗领域有望迎来更多的突破和创新。一方面,科研人员可能会研发出更多针对 ROS1 肺癌的特效药物,这些药物或许能够更精准地作用于癌细胞,进一步提高治疗效果,降低副作用。另一方面,联合治疗方案也可能成为未来的重要发展方向,例如将瑞普替尼与其他药物(如免疫治疗药物、化疗药物等)联合使用,通过不同药物的协同作用,增强对肿瘤细胞的杀伤能力,为患者带来更好的治疗效果。此外,随着基因检测技术的不断进步,对于 ROS1 肺癌的诊断将更加精准,能够更早地发现疾病,为患者争取更多的治疗时间。我们有理由相信,在医学的不断进步和全社会的共同努力下,肺癌患者的生存状况将得到持续改善,最终实现战胜肺癌的目标。
免责声明:本微信公众号中的内容仅供一般参考,不可直接作为决策依据
👆点击给个关注吧~👆
------------------ END ------------------
购买正规的药品,保障身体健康:
那如何购买正规的海外药品呢?
购买海外产品时,建议选择正规渠道,如通过认证的平台或医疗机构购买。选择有正规药品经营许可公示的跨境药企,不要通过非法代购购买,注意保证货品来源正宗。同时,注意查看产品的包装和说明书,确保购买到的是正品,并遵循正确的用药指导。
药品咨询服务👇 在线人工客服👇

长图图片识别二维码联系在线客服
或点击下方阅读原文,咨询在线客服
仁和(香港)医药集团,为患者健康,争分夺秒,保驾护航!
// 香港仁和医药集团
”
总的来说,患者想要安全的用上新药,一定要按照正规流程、途径来,选择拥有政府颁发合法资质的公司。
香港仁和医药集团是香港卫生署注册正规持牌药品批发商,销售集团商,具有完备的进出口资质以确保货物安全进出口,可为癌症病患者提供医药进出口服务,药物的来源及去向,全程接受卫生署监管。
------ END ------
关注我们,追踪医药最新动态!